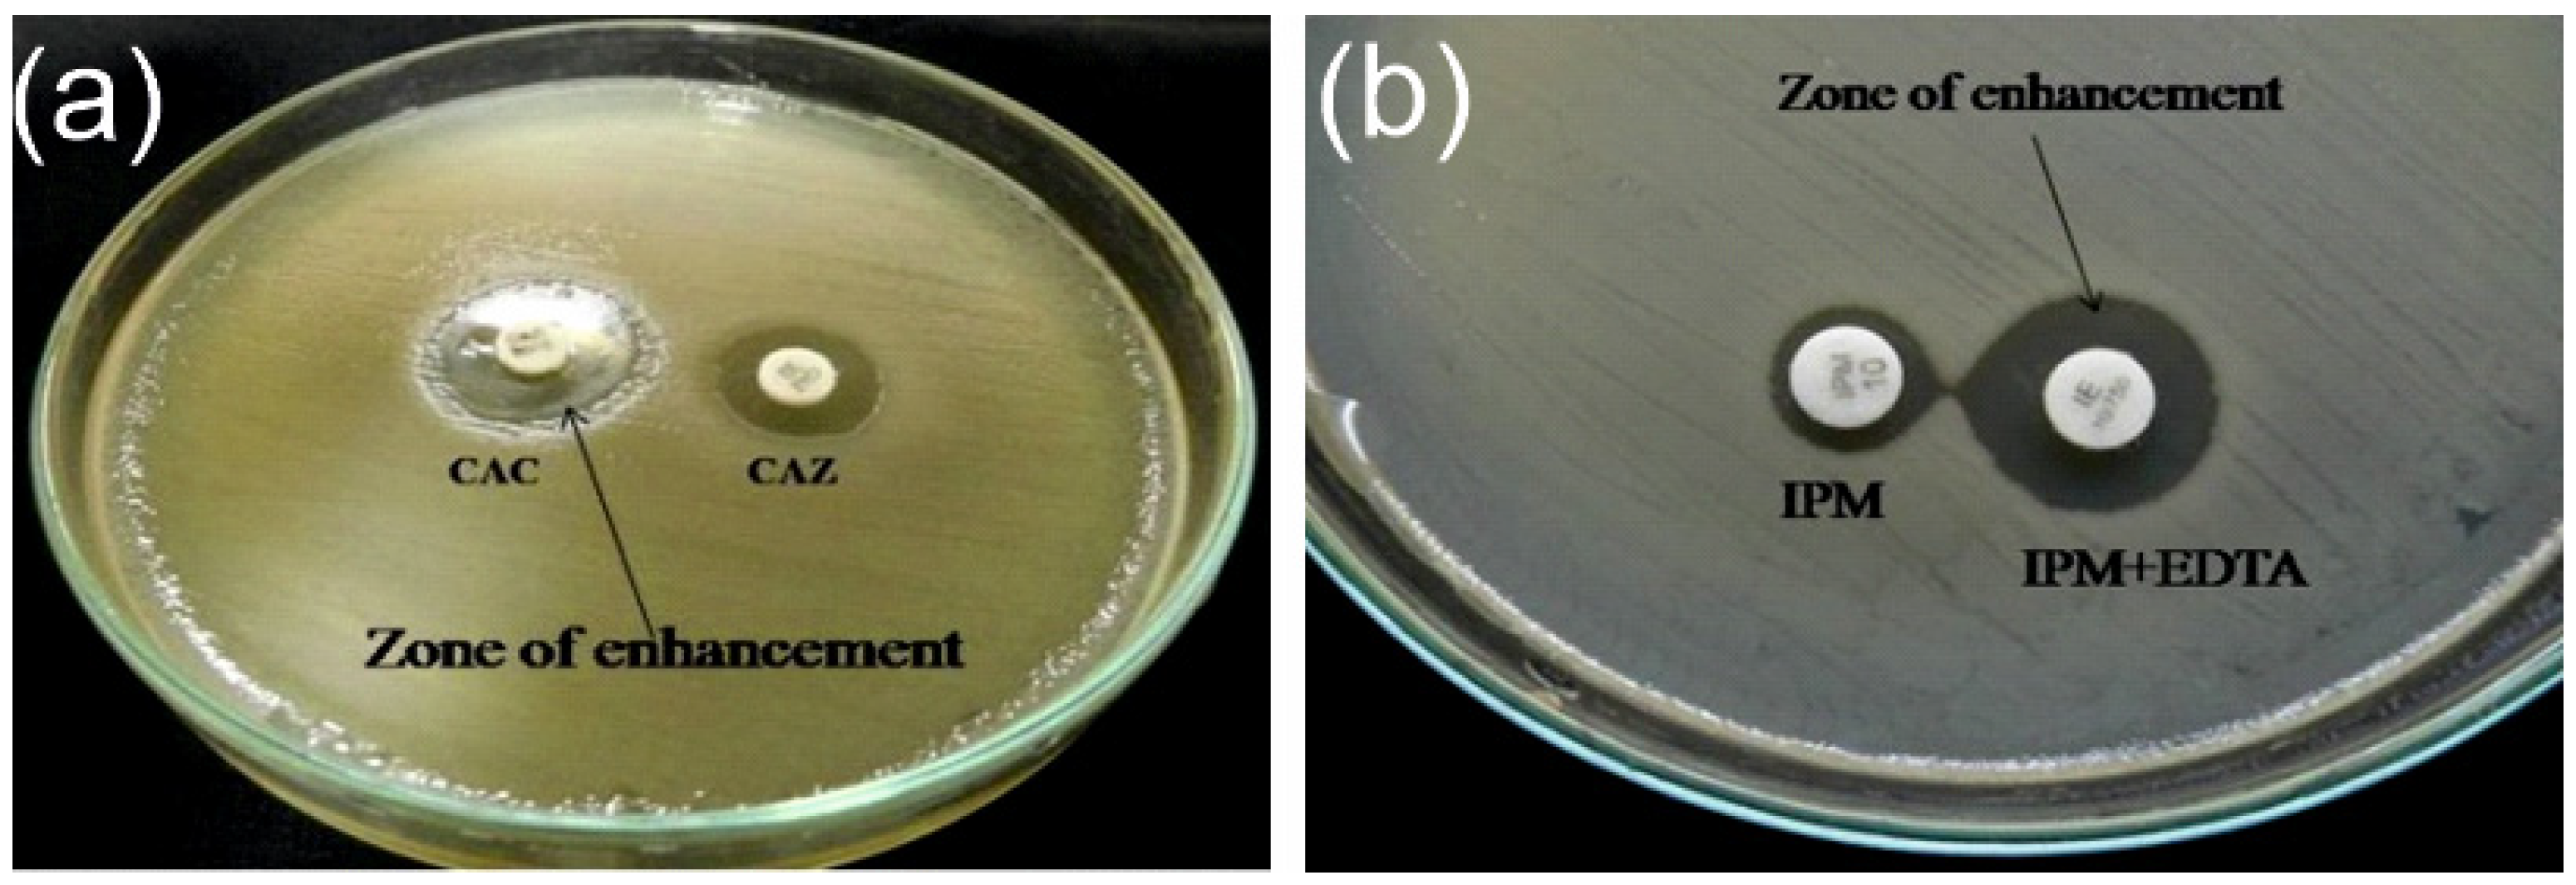
Bacteria 04 00024 g001

Antimicrobial Resistance and Prevalence of β-lactamase Genes Among Multidrug-Resistant Acinetobacter baumannii Isolates from Infected Diabetic Foot Ulcers
Abstract
1. Introduction
2. Materials and Methods
2.1. Sample Collection
2.2. Bacterial Isolation and Antibiogram Profile of A. baumannii
2.3. Extended Spectrum β-lactamase and Metallo-β-lactamase
2.4. DNA Extraction and Multiplex qPCR
2.5. Statistical Analysis
3. Results
3.1. Patient Characteristics
3.2. Antimicrobial Susceptibility and ESBL/MBL Detection
3.3. Multiplex qPCR
4. Discussion
5. Conclusions
Supplementary Materials
Author Contributions
Funding
Institutional Review Board Statement
Informed Consent Statement
Data Availability Statement
Conflicts of Interest
References
- Cigna, E.; Fino, P.; Onesti, M.G.; Amorosi, V.; Scuderi, N. Diabetic foot infection treatment and care. Int. Wound J. 2016, 13, 238–242. [Google Scholar] [CrossRef] [PubMed]
- Lauri, C.; Leone, A.; Cavallini, M.; Signore, A.; Giurato, L.; Uccioli, L. Diabetic foot infections: The diagnostic challenges. J. Clin. Med. 2020, 9, 1779. [Google Scholar] [CrossRef]
- Noor, S.; Khan, R.U.; Ahmad, J. Understanding diabetic foot infection and its management. Diabetes Metab. Syndr. 2017, 11, 149–156. [Google Scholar] [CrossRef] [PubMed]
- Burgess, J.L.; Wyant, W.A.; Abdo Abujamra, B.; Kirsner, R.S.; Jozic, I. Diabetic wound-healing science. Medicina 2021, 57, 1072. [Google Scholar] [CrossRef]
- McDermott, K.; Fang, M.; Boulton, A.J.M.; Selvin, E.; Hicks, C.W. Etiology, epidemiology, and disparities in the burden of diabetic foot ulcers. Diabetes Care 2023, 46, 209–221. [Google Scholar] [CrossRef] [PubMed]
- Edmonds, M.; Manu, C.; Vas, P. The current burden of diabetic foot disease. J. Clin. Orthop. Trauma. 2021, 17, 88–93. [Google Scholar] [CrossRef]
- Hadi, P.; Rampal, S.; Neela, V.K.; Cheema, M.S.; Sarawan Singh, S.S.; Kee Tan, E.; Sinniah, A. Distribution of causative microorganisms in diabetic foot infections: A ten-year retrospective study in a tertiary care hospital in central Malaysia. Antibiotics 2023, 12, 687. [Google Scholar] [CrossRef] [PubMed]
- Turhan, V.; Mutluoglu, M.; Acar, A.; Hatipoglu, M.; Onem, Y.; Uzun, G.; Ay, H.; Oncul, O.; Gorenek, L. Increasing incidence of Gram-negative organisms in bacterial agents isolated from diabetic foot ulcers. J. Infect. Dev. Ctries. 2013, 7, 707–712. [Google Scholar] [CrossRef]
- El-Hazmi, M.M. Bacteriological profile of diabetic foot infections in a teaching hospital in Saudi Arabia. J. Pure Appl. Microbiol. 2015, 9, 1933–1943. [Google Scholar]
- Jouhar, L.; Jaafar, R.F.; Nasreddine, R.; Itani, O.; Haddad, F.; Rizk, N.; Hoballah, J.J. Microbiological profile and antimicrobial resistance among diabetic foot infections in Lebanon. Int. Wound J. 2020, 17, 1764–1773. [Google Scholar] [CrossRef]
- Alhubail, A.; Sewify, M.; Messenger, G.; Masoetsa, R.; Hussain, I.; Nair, S.; Tiss, A. Microbiological profile of diabetic foot ulcers in Kuwait. PLoS ONE 2020, 15, e0244306. [Google Scholar] [CrossRef] [PubMed]
- Qu, Y.D.; Ou, S.J.; Zhang, W.; Li, J.X.; Xia, C.L.; Yang, Y.; Liu, J.B.; Ma, Y.F.; Jiang, N.; Wang, Y.Y.; et al. Microbiological profile of diabetic foot infections in China and worldwide: A 20-year systematic review. Front. Endocrinol. 2024, 15, 1368046. [Google Scholar] [CrossRef] [PubMed]
- Al Benwan, K.; Al Mulla, A.; Rotimi, V.O. A study of the microbiology of diabetic foot infections in a teaching hospital in Kuwait. J. Infect. Public Health 2012, 5, 1–8. [Google Scholar] [CrossRef]
- Son, S.T.; Han, S.K.; Lee, T.Y.; Namgoong, S.; Dhong, E.S. The microbiology of diabetic foot infections in Korea. J. Wound Manag. Res. 2017, 13, 8–12. [Google Scholar] [CrossRef]
- Sannathimmappa, M.B.; Nambiar, V.; Aravindakshan, R.; Al Khabori, M.S.; Al-Flaiti, A.H.; Al-Azri, K.N.; Al-Reesi, A.K.; Al Kiyumi, A.R. Diabetic foot infections: Profile and antibiotic susceptibility patterns of bacterial isolates in a tertiary care hospital of Oman. J. Educ. Health Promot. 2021, 10, 254. [Google Scholar] [CrossRef] [PubMed]
- Hitam, S.A.; Asma’Hassan, S.; Maning, N.U. The significant association between polymicrobial diabetic foot infection and its severity and outcomes. Malays. J. Med. Sci. 2019, 26, 107. [Google Scholar] [CrossRef]
- Sun, H.; Ma, Y.; Heng, H.; Liu, X.; Liang, J.; Geng, H. Microbiological Distribution, Antimicrobial Susceptibility and Risk Factors of Polymicrobial Infections in Diabetic Foot. Clin. Lab. 2024, 70. [Google Scholar] [CrossRef]
- Howard, A.; O’Donoghue, M.; Feeney, A.; Sleator, R.D. Acinetobacter baumannii: An emerging opportunistic pathogen. Virulence 2012, 3, 243–250. [Google Scholar] [CrossRef]
- Lahiri, K.K.; Mani, N.S.; Purai, S.S. Acinetobacter spp as nosocomial pathogen: Clinical significance and antimicrobial sensitivity. Med. J. Armed Forces India 2004, 60, 7–10. [Google Scholar] [CrossRef]
- Bali, N.K.; Fomda, B.A.; Bashir, H.; Zahoor, D.; Lone, S.; Koul, R.A. Emergence of carbapenem-resistant Acinetobacter in a temperate north Indian State. Br. J. Biomed. Sci. 2013, 70, 156–160. [Google Scholar] [CrossRef]
- Khan, D.M.; Manzoor, M.A.; Rao, I.V.; Moosabba, M.S. Evaluation of biofilm formation, cell surface hydrophobicity and gelatinase activity in Acinetobacter baumannii strains isolated from patients of diabetic and non-diabetic foot ulcer infections. Biocatal. Agric. Biotechnol. 2019, 18, 101007. [Google Scholar] [CrossRef]
- Zarrilli, R.; Pournaras, S.; Giannouli, M.; Tsakris, A. Global evolution of multidrug-resistant Acinetobacter baumannii clonal lineages. Int. J. Antimicrob. Agents 2013, 41, 11–19. [Google Scholar] [CrossRef] [PubMed]
- Kyriakidis, I.; Vasileiou, E.; Pana, Z.D.; Tragiannidis, A. Acinetobacter baumannii antibiotic resistance mechanisms. Pathogens 2021, 10, 373. [Google Scholar] [CrossRef] [PubMed]
- Gupta, V. An update on newer β-lactamases. Indian J. Med. Res. 2007, 126, 417–427. [Google Scholar]
- Goel, V.; Hogade, S.A.; Karadesai, S.G. Prevalence of extended-spectrum beta-lactamases, AmpC beta-lactamase, and metallo-beta-lactamase producing Pseudomonas aeruginosa and Acinetobacter baumannii in an intensive care unit in a tertiary care hospital. J. Sci. Soc. 2013, 40, 28–31. [Google Scholar] [CrossRef]
- Humphries, R.M.; Ambler, J.; Mitchell, S.L.; Castanheira, M.; Dingle, T.; Hindler, J.A.; Koeth, L.; Sei, K. CLSI methods development and standardization working group best practices for evaluation of antimicrobial susceptibility tests. J. Clin. Microbiol. 2018, 56, 10–128. [Google Scholar] [CrossRef]
- Andrews, J.M. Determination of minimum inhibitory concentrations. J. Antimicrob. Chemother. 2001, 48 (Suppl. S1), 5–16. [Google Scholar] [CrossRef]
- Manisha, J.; Mitesh, P.H.; Nidhi, S.K.; Modi, D.J.; Vegad, M.M. Spectrum of Microbial Flora in Diabetic Foot Ulcer and Antibiotic Sensitivity Pattern in Tertiary Care Hospital in Ahmedabad, Gujarat. Nat. J. Med. Res. 2012, 3, 354–357. [Google Scholar]
- Sekhar, S.; Unnikrishnan, M.K.; Rodrigues, G.S.; Vyas, N.; Mukhopadhyay, C. Antimicrobial susceptibility pattern of aerobes in diabetic foot ulcers in a South-Indian tertiary care hospital. Foot 2018, 37, 95–100. [Google Scholar] [CrossRef] [PubMed]
- Iacopi, E.; Pieruzzi, L.; Riitano, N.; Abbruzzese, L.; Goretti, C.; Piaggesi, A. The weakness of the strong sex: Differences between men and women affected by diabetic foot disease. Int. J. Low. Extrem. Wounds 2023, 22, 19–26. [Google Scholar] [CrossRef]
- Sahu, S.S.; Chaudhary, V.; Sharma, N.; Kumari, S.; Pal, B.; Khurana, N. Prevalence and risk factors associated with diabetic foot ulcer in India: A systematic review and meta-analysis. Int. J. Infect. Dev. Ctries. 2024. [Google Scholar] [CrossRef]
- Castellanos, N.; Nakanouchi, J.; Yüzen, D.I.; Fung, S.; Fernandez, J.S.; Barberis, C.; Tuchscherr, L.; Ramirez, M.S. A study on Acinetobacter baumannii and Staphylococcus aureus strains recovered from the same infection site of a diabetic patient. Curr. Microbiol. 2019, 76, 842–847. [Google Scholar] [CrossRef] [PubMed]
- Isler, B.; Keske, Ş.; Aksoy, M.; Azap, Ö.K.; Yilmaz, M.; Yavuz, S.Ş.; Aygün, G.; Tigen, E.; Akalın, H.; Azap, A.; et al. Antibiotic overconsumption and resistance in Turkey. Clin. Microbiol. Infect. 2019, 25, 651–653. [Google Scholar] [CrossRef] [PubMed]
- Moghnieh, R.A.; Kanafani, Z.A.; Tabaja, H.Z.; Sharara, S.L.; Awad, L.S.; Kanj, S.S. Epidemiology of common resistant bacterial pathogens in the countries of the Arab League. Lancet Infect. Dis. 2018, 18, e379–e394. [Google Scholar] [CrossRef]
- European Centre for Disease Prevention and Control. Antimicrobial Resistance in the EU/EEA (EARS-Net)—Annual Epidemiological Report 2020. Stockholm: ECDC. 2022. Available online: https://www.ecdc.europa.eu/en/publications-data/surveillance-antimicrobial-resistance-europe-2022 (accessed on 1 March 2025).
- Tacconelli, E.; Carrara, E.; Savoldi, A.; Harbarth, S.; Mendelson, M.; Monnet, D.L.; Pulcini, C.; Kahlmeter, G.; Kluytmans, J.; Carmeli, Y.; et al. Discovery, research, and development of new antibiotics: The WHO priority list of antibiotic-resistant bacteria and tuberculosis. Lancet Infect. Dis. 2018, 18, 318–327. [Google Scholar] [CrossRef]
- Zaki, M.E.; Abou ElKheir, N.; Mofreh, M. Molecular study of quinolone resistance determining regions of gyrA gene and parC genes in clinical isolates of Acintobacter baumannii resistant to fluoroquinolone. Open Microbiol. J. 2018, 12, 116. [Google Scholar] [CrossRef]
- Vázquez-López, R.; Solano-Gálvez, S.G.; Juárez Vignon-Whaley, J.J.; Abello Vaamonde, J.A.; Padró Alonzo, L.A.; Rivera Reséndiz, A.; Muleiro Álvarez, M.; Vega López, E.N.; Franyuti-Kelly, G.; Álvarez-Hernández, D.A.; et al. Acinetobacter baumannii resistance: A real challenge for clinicians. Antibiotics 2020, 9, 205. [Google Scholar] [CrossRef] [PubMed]
- Li, L.; Hassan, K.A.; Tetu, S.G.; Naidu, V.; Pokhrel, A.; Cain, A.K.; Paulsen, I.T. The transcriptomic signature of tigecycline in Acinetobacter baumannii. Front. Microbiol. 2020, 11, 565438. [Google Scholar] [CrossRef]
- Safari, M.; Nejad, A.S.; Bahador, A.; Jafari, R.; Alikhani, M.Y. Prevalence of ESBL and MBL encoding genes in Acinetobacter baumannii strains isolated from patients of intensive care units (ICU). Saudi J. Biol. Sci. 2015, 22, 424–429. [Google Scholar] [CrossRef]
- Ranjbar, R.; Tolon, S.S.; Zayeri, S.; Sami, M. The frequency of antibiotic resistance and ESBLs among clinically Acinetobacter baumannii strains isolated from patients in a major hospital in Tehran, Iran. Open Microbiol. J. 2018, 12, 254. [Google Scholar] [CrossRef]
- Farajnia, S.; Azhari, F.; Alikhani, M.Y.; Hosseini, M.K.; Peymani, A.; Sohrabi, N. Prevalence of PER and VEB type extended spectrum betalactamases among multidrug resistant Acinetobacter baumannii isolates in North-West of Iran. Iran. J. Basic Med. Sci. 2013, 16, 751. [Google Scholar] [PubMed]
- Azizi, M.; Mortazavi, S.H.; Etemadimajed, M.; Gheini, S.; Vaziri, S.; Alvandi, A.; Kashef, M.; Ahmadi, K. Prevalence of extended-spectrum β-Lactamases and antibiotic resistance patterns in Acinetobacter baumannii isolated from clinical samples in Kermanshah, Iran. Jundishapur J. Microbiol. 2017, 10, e61522. [Google Scholar] [CrossRef]
- Zarabadi-Pour, M.; Peymani, A.; Habibollah-Pourzereshki, N.; Sarookhani, M.R.; Karami, A.A.; Javadi, A. Detection of extended-spectrum ß-lactamases among Acinetobacter baumannii isolated from hospitals of Qazvin, Iran. Ethiop. J. Health Sci. 2021, 31, 229–236. [Google Scholar] [CrossRef] [PubMed]

| All | Males | Females | Difference Between Males and Females | ||
|---|---|---|---|---|---|
| 480 (100.00%) | 365 (76%) | 115 (24%) | p a | ||
| Age, y | 56.5 (11.4) | 56.9 (11.1) | 55.1 (12.3) | 0.116 | |
| Wagner Grade, n (%) | Grade 2 | 98 (20.5) | 70 (19.2) | 28 (24.4) | 0.237 |
| Grade 3 | 199 (40.3) | 154 (42.2) | 45 (39.1) | ||
| Grade 4 | 147 (30.7) | 117 (35.5) | 30 (26.1) | ||
| Grade 5 | 36 (7.5) | 24 (6.6) | 12 (10.4) | ||
| Diabetes mellitus, n (%) | 480 (100.00) | 365 (76) | 115 (24) | - | |
| Hypertension, n (%) | 249 (51.9) | 182 (49.9) | 67 (58.3) | 0.071 | |
| Ischemic heart disease, n (%) | 80 (16.7) | 63 (17.3) | 17 (14.8) | 0.321 | |
| Peripheral vascular disease, n (%) | 300 (62.5) | 226 (61.9) | 74 (64.3) | 0.361 | |
| Retinopathy, n (%) | 275 (57.7) | 211 (55.8) | 64 (55.7) | 0.443 | |
| Nephropathy, n (%) | 85 (17.7) | 68 (18.6) | 17 (14.8) | 0.213 | |
| Smoking, n (%) | 263 (54.8) | 260 (71.2) | 3 (2.6) | <0.001 | |
| Alcohol use, n (%) | 218 (45.4) | 215 (58.9) | 3 (2.6) | <0.001 | |
| Haemoglobin, (g/dL) | 10.9 (4.8) | 11.2 (5.4) | 10.1 (1.8) | 0.032 | |
| Random blood sugar, (mg/dL) | 251.8 (104.5) | 243.6 (99.6) | 277.6 (115.3) | <0.001 | |
| Fasting blood sugar, (mg/dL) | 141.2 (65.2) | 135.9 (63.1) | 115 (68.9) | 0.002 | |
| Postprandial blood sugar, (mg/dL) | 199.8 (94.2) | 189.6 (86.8) | 232.1 (108.7) | <0.001 | |
| Urine ketone bodies, (mg/dL) | 70 (14.6) | 46 (12.6) | 24 (20.9) | 0.034 | |
| Antibiotics | Sensitive | Moderate or Intermediate Sensitive | Resistant |
|---|---|---|---|
| β-lactams | |||
| Aminoglycosides | |||
| Amikacin (30 µg) | 2 (2.9%) | 0 | 68 (97%) |
| Gentamicin (10 µg) | 3 (4.3%) | 0 | 67 (95.7%) |
| Tobramycin (10 µg) | 5 (7.1%) | 0 | 65 (92.9%) |
| Carbapenems | |||
| Imipenem (10 µg) | 6 (8.6%) | 0 | 64 (91.4%) |
| Meropenem (10 µg) | 8 (11.4%) | 0 | 62 (88.6%) |
| Cephalosporins | |||
| Cefepime (30 µg) | 0 | 0 | 70 (100%) |
| Ceftazidime (30 µg) | 0 | 0 | 70 (100%) |
| Cefotaxime (30 µg) | 2 (2.9%) | 0 | 68 (97%) |
| Ceftriaxone (30 µg) | 0 | 0 | 70 (100%) |
| Fluroquinolones | |||
| Ciprofloxacin (5 µg) | 4 (5.7%) | 0 | 66 (94.3) |
| Levofloxacin (5 µg) | 4 (5.7%) | 3 (4.3%) | 63 (90%) |
| Penicillins | |||
| Piperacillin (100 µg) | 1 (1.4%) | 0 | 69 (98.6%) |
| Tetracycline (30 µg) | 3 (4.3%) | 1(1.4%) | 66 (94.3%) |
| Folate-pathway inhibitors | |||
| Trimethoprim/sulfamethoxazole (25 µg) | 4 (5.7%) | 0 | 66 (94.3%) |
| Β-lactam inhibitor combinations | |||
| Piperacillin/tazobactam (30 µg) | 4 (5.7%) | 3 (4.3%) | 63 (90%) |
| Gene | ESBL Producer (n = 17) | Non-ESBL Producer (n = 17) | MBL Producer (n = 17) Producer (n = 17) | Non-MBL Producer (n = 17) |
|---|---|---|---|---|
| blaCTX-M | 1 (5.88%) | 1 (5.88%) | - | - |
| blaSHV | 0 | 0 | - | - |
| blaTEM | 9 (52.94%) | 5 (29.41%) | - | - |
| blaCTX-M + SHV + TEM | 1 (5.88%) | 1 (5.88%) | - | - |
| blaSHV + blaTEM | 1 (5.88%) | 3 (17.64%) | - | - |
| blaCTX-M + blaSHV | 0 | 1 (5.88%) | - | - |
| blaIMP | - | - | 0 | 0 |
| blaVIM | - | - | 0 | 0 |
| blaNDM-1 | - | - | 9 (52.94%) | 10 (58.82%) |
| blaIMP+ VIM + NDM-1 | - | - | 1 (5.88%) | 0 |
| blaVIM + blaNDM-1 | - | - | 0 | 1 (5.88%) |
| blaIMP + blaVIM | - | - | 1 (5.88%) | 2 (11.76%) |
| blaIMP + blaNDM-1 | - | - | 3 (17.64%) | 2 (11.76%) |
| Total | 12 (70.59%) | 11 (64.70%) | 14 (82.35%) | 15 (88.24%) |
Disclaimer/Publisher’s Note: The statements, opinions and data contained in all publications are solely those of the individual author(s) and contributor(s) and not of MDPI and/or the editor(s). MDPI and/or the editor(s) disclaim responsibility for any injury to people or property resulting from any ideas, methods, instructions or products referred to in the content. |
© 2025 by the authors. Licensee MDPI, Basel, Switzerland. This article is an open access article distributed under the terms and conditions of the Creative Commons Attribution (CC BY) license (https://creativecommons.org/licenses/by/4.0/).
Share and Cite
Khan, D.M.; Rao, V.I.; Moosabba, M.S.; MubarakAli, D.; Manzoor, M. Antimicrobial Resistance and Prevalence of β-lactamase Genes Among Multidrug-Resistant Acinetobacter baumannii Isolates from Infected Diabetic Foot Ulcers. Bacteria 2025, 4, 24. https://doi.org/10.3390/bacteria4020024
Khan DM, Rao VI, Moosabba MS, MubarakAli D, Manzoor M. Antimicrobial Resistance and Prevalence of β-lactamase Genes Among Multidrug-Resistant Acinetobacter baumannii Isolates from Infected Diabetic Foot Ulcers. Bacteria. 2025; 4(2):24. https://doi.org/10.3390/bacteria4020024
Chicago/Turabian StyleKhan, Diwan Mahmood, Venkatakrishna I. Rao, M. S. Moosabba, Davoodbasha MubarakAli, and Muhammed Manzoor. 2025. "Antimicrobial Resistance and Prevalence of β-lactamase Genes Among Multidrug-Resistant Acinetobacter baumannii Isolates from Infected Diabetic Foot Ulcers" Bacteria 4, no. 2: 24. https://doi.org/10.3390/bacteria4020024
APA StyleKhan, D. M., Rao, V. I., Moosabba, M. S., MubarakAli, D., & Manzoor, M. (2025). Antimicrobial Resistance and Prevalence of β-lactamase Genes Among Multidrug-Resistant Acinetobacter baumannii Isolates from Infected Diabetic Foot Ulcers. Bacteria, 4(2), 24. https://doi.org/10.3390/bacteria4020024







